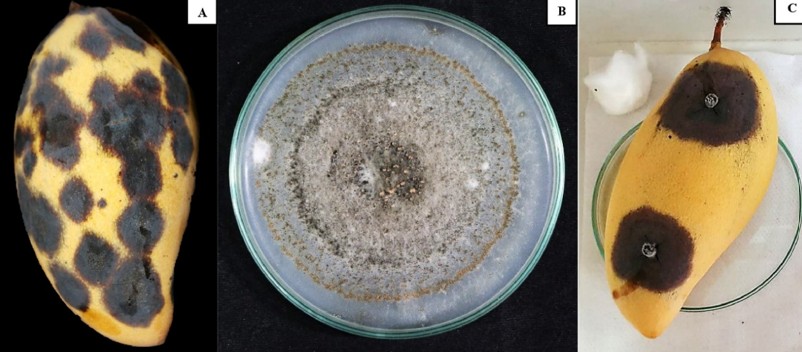

El mango (Mangifera indica L familia Anacardiaceae), es uno de los principales cultivos frutales tropicales y subtropicales.
Es una fruta climatérica que experimenta cambios fisiológicos y bioquímicos pronunciados durante la maduración, caracterizados por un aumento brusco de la tasa de respiración y la producción de etileno.
Estos procesos aceleran la maduración y contribuyen a su vida relativamente corta poscosecha.
En los últimos años, se han explorado diversas tecnologías, incluido el almacenamiento a baja temperatura, para prolongar su vida útil. Sin embargo, la eficacia del almacenamiento en frío es limitada debido a que los mangos son propensos a sufrir daños a bajas temperaturas, cuando se almacenan a menos de 13 °C. Esta exposición suele provocar trastornos fisiológicos externos e internos que comprometen la calidad de la fruta.
Los trastornos típicos poscosecha incluyen ablandamiento, decoloración de la piel, desarrollo de sabores desagradables y descomposición microbiana durante el almacenamiento.
Entre estos, la antracnosis, causada por Colletotrichum gloeosporioides, es una de las enfermedades más destructivas, reduciendo sustancialmente la comercialización.
Además, el almacenamiento se acompaña de marcadas alteraciones bioquímicas, como fluctuaciones en el contenido fenólico y cambios en el equilibrio azúcar-ácido, que pueden comprometer el sabor, la calidad nutricional y la capacidad antioxidante.
En los últimos años, la irradiación ultravioleta-C (UV-C; 200–280 nm) ha ganado cada vez más atención como un enfoque sostenible y libre de químicos para el tratamiento poscosecha. Cuando se aplica en dosis adecuadas, la UV-C puede inhibir el crecimiento microbiano, retrasar la maduración y preservar la calidad de la fruta.
Muchos estudios han reportado la eficacia del tratamiento UV-C para extender la vida útil de varias frutas, incluyendo arándanos, fresas, piñas y mangos, con rangos de dosis efectivas de 0.03 a 39.3 kJ·m⁻².
Estos hallazgos sugieren que la integración de la irradiación UV-C con el almacenamiento a baja temperatura representa una estrategia prometedora para mejorar la calidad poscosecha y reducir las pérdidas en los frutos de mango.
Un estudio actual tuvo como objetivo investigar los efectos de diferentes dosis de irradiación UV-C en los atributos de calidad poscosecha, la actividad antioxidante y la incidencia de enfermedades de los mangos durante el almacenamiento en frío.
En esta investigación se analizaron los efectos de diferentes exposiciones a la radiación UV-C a 0, 2,47, 4,93 y 7,37 kJ·m⁻² sobre calidad, la supresión de enfermedades y las propiedades antioxidantes de los mangos almacenados a 15 ± 2 °C durante 21 días.
Los tratamientos con UV-C redujeron significativamente la pérdida de peso, mantuvieron la firmeza y retrasaron los cambios de color de la cáscara en comparación con el control sin tratamiento, con 2,47 y 4,93 kJ·m⁻² mostrando la mayor eficacia.
La irradiación UV-C también suprimió el desarrollo de antracnosis (Colletotrichum gloeosporioides), lo que resultó en una menor gravedad de la enfermedad.
La capacidad antioxidante, evaluada mostró respuestas dependientes de la dosis y el tiempo.
Síntomas de antracnosis observados en mangos infectados por C.gloeosporioides (A).
Morfología de colonias de cultivadas en medio de cultivo durante 7 días a 28 ± 2 °C. (B).
Desarrollo de lesiones de antracnosis en mangos 7 días después de la inoculación artificial (C).
En general, estos hallazgos destacan que el tratamiento con UV-C es una prometedora estrategia poscosecha ecológica para mejorar la resistencia a enfermedades y preservar la calidad de la fruta de mango.
A diferencia de los tratamientos térmicos o fungicidas convencionales, la irradiación UV-C representa una tecnología sin residuos que puede optimizarse tanto para la conservación de la calidad como para el control de enfermedades.
Phannakham, N.; Saepaisan, S.; Hongpakdee.; Ayutthaya, S. I.; N.; A.; Lin, H. L.; Nampila, S. (2026).
Influences of UV-C radiation on quality, antioxidant and disease control in ‘Nam Dok Mai Sithong’ mangoes during low temperature storage
Scientia Horticulturae ,355: 114595.
https://www.sciencedirect.com/science/article/pii/S0304423825006429 Acceso 16/03/2026.
https://doi.org/10.1016/j.scienta.2025.114595 el16/03/2026.
Imagen
https://news.umiamihealth.org/en/the-health-benefits-of-mangoes/ el16/03/2026.